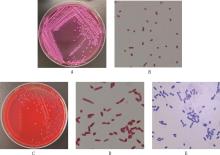

China Animal Husbandry & Veterinary Medicine ›› 2026, Vol. 53 ›› Issue (2): 903-915.doi: 10.16431/j.cnki.1671-7236.2026.02.035
• Zoonoses • Previous Articles Next Articles
ZHANG Sui1,2( ), CHENG Chunjie1,3(
), CHENG Chunjie1,3( ), YANG Chun1,4, CHEN Mengjiao1,4, CHENG Jing1, ZHOU Linyi1, LI Yongqing1, WANG Xiaoying2(
), YANG Chun1,4, CHEN Mengjiao1,4, CHENG Jing1, ZHOU Linyi1, LI Yongqing1, WANG Xiaoying2( ), LIU Wenxiao1,5(
), LIU Wenxiao1,5( )
)
Revised:2025-05-13
Online:2026-02-20
Published:2026-01-27
Contact:
WANG Xiaoying, LIU Wenxiao
E-mail:2324212625@qq.com;ccj20200202@163.com;wangxiaoying6969@126.com;lwx232210809@163.com
CLC Number:
ZHANG Sui, CHENG Chunjie, YANG Chun, CHEN Mengjiao, CHENG Jing, ZHOU Linyi, LI Yongqing, WANG Xiaoying, LIU Wenxiao. Isolation, Identification and Pathogenicity Analysis of Dairy Cow-derived Klebsiella pneumoniae and Mannheimia haemolytica[J]. China Animal Husbandry & Veterinary Medicine, 2026, 53(2): 903-915.
Table 1
Primer information"
目的基因 Target genes | 引物序列 Primer sequences (5′→3′) | 产物长度 Product length/bp | 退火温度 Annealing temperature/℃ | 参考文献 References |
|---|---|---|---|---|
| 16S rRNA | 27-F: AGAGTTTGATCCTGGCTCAG | 1 542 | 55 | Weisburg等[ |
| 1492-R: GGTTACCTTGTTACGACTT | ||||
| Khe | F: TGATTGCATTCGCCACTGG | 428 | 60 | Yin-Ching等[ |
| R: GGTCAACCCAACGATCCTG | ||||
| 16S rRNA | Mh-F: ACGGTAGCACATAGGAGT | 453 | 56 | Griffin[ |
| (溶血性曼氏杆菌 M.haemolytic) | Mh-R:TATTACCGCGGCTGCTG | |||
| rmpA2 | F: GTGCAATAAGGATGTTACATTA | 430 | 50 | Russo等[ |
| R: GGATGCCCTCCTCCTG | ||||
| iuc | F: GCTTATTTCTCCCCAACCC | 583 | 59 | |
| R: TCAGCCCTTTAGCGACAAG | ||||
| rmpA | F: GAGTAGTTAATAAATCAATAGCAAT | 332 | 50 | |
| R: CAGTAGGCATTGCAGCA | ||||
| magA | F: GGTGCTCTTTACATCATTGC | 1 282 | 59 | Candan等[ |
| R: GCAATGGCCATTTGCGTTAG | ||||
| wcaG | F: GGTTGGKTCAGCAATCGTA | 169 | 54 | |
| R: ACTATTCCGCCAACTTTTGC | ||||
| allS | F: CCGAAACATTACGCACCTTT | 508 | 57 | |
| R: ATCACGAAGAGCCAGGTCAC | ||||
| wabG | F: ACCATCGGCCATTTGATAGA | 683 | 58 | |
| R: CGGACTGGCAGATCCATATC | ||||
| fimH | F: GCTCTGGCCGATACCACCACGG | 423 | 60 | 邹鹏等[ |
| R: GCGAAGTAACGTGCCTGGAACGG | ||||
| mrkD | F: CCACCAACTATTCCCTCGAA | 226 | 62 | El-Domany等[ |
| R: ATGGAACCCACATCGACATT | ||||
| kfu | F: GAAGTGACGCTGTTTCTGGC | 797 | 54 | |
| R: TTTCGTGTGGCCAGTGACTC | ||||
| uge | F: TCTTCACGCCTTCCTTCACT | 534 | 54 | |
| R: GATCATCCGGTCTCCCTGTA | ||||
| entB | F: ATTTCCTCAACTTCTGGGGC | 371 | 57 | El Fertas-Aissani等[ |
| R:AGCATCGGTGGCGGTGGTCA | ||||
| ycf | F: ATCAGCAGTCGGGTCAGC | 160 | 55 | |
| R: CTTCTCCAGCATTCAGCG | ||||
| ybtA | F: ATGACGGAGTCACCGCAAAC | 960 | 55 | 徐水宝等[ |
| R: TTACATCACGCGTTTAAAGG | ||||
| ureA | F: GCTGACTTAAGAGAACGTTATG | 337 | 50 | 和晋渝[ |
| R: GATCATGGCGCTACCTCTA | ||||
| iroN | F: GTCCGGCGGTAACTTCAGCC | 829 | 58 | 高淩[ |
| R: TCAGAATGAAACTACCGCCC |
Fig.1
Colony morphology and staining microscopy results of the isolatesA and B, Colony morphology of milk isolate on MacConkey agar and Gram staining (1 000×), respectively; C and D, Colony morphology of blood isolate on blood agar and Gram staining (1 000×), respectively;E, Wright-Giemsa staining of bacteria in blood sample (1 000×)"

Table 2
Antimicrobial susceptibility test results of the isolates"
抗菌药 Antimicrobials | 含量 Content/ (μg/片) | 肺炎克雷伯菌 K. pneumoniae | 溶血性曼氏杆菌 M. haemolytica | ||
|---|---|---|---|---|---|
| 抑菌圈直径IZD/mm | 结果Results | 抑菌圈直径IZD/mm | 结果Results | ||
| 恩诺沙星 Enrofloxacin | 5 | 30.67±0.29 | S | 24.51±0.45 | S |
| 环丙沙星 Ciprofloxacin | 5 | 24.03±0.05 | I | 22.72±0.24 | S |
| 左氧氟沙星 Levofloxacin | 5 | 25.00±0.00 | S | 23.19±0.25 | S |
| 萘啶酸 Nalidxic Acid | 30 | 13.05±0.05 | R | 21.37±0.56 | S |
| 诺氟沙星 Norfloxacin | 10 | 27.05±0.90 | S | 21.18±0.80 | S |
| 氟苯尼考 Florfenicol | 30 | 25.01±0.39 | S | 22.25±0.55 | S |
| 阿奇霉素 Azithromycin | 15 | 15.10±0.40 | S | 20.25±0.16 | S |
| 强力霉素 Doxycycline | 30 | 18.83±0.14 | S | 19.14±0.12 | S |
| 四环素 Tetracycline | 30 | 21.50±0.50 | S | 21.49±0.15 | S |
| 大观霉素 Spectinomycin | 100 | 19.00±0.00 | S | 12.63±0.07 | I |
| 丁胺卡那 Amikacin | 30 | 19.00±0.24 | I | 13.93±0.21 | I |
| 庆大霉素 Gentamicin | 10 | 21.50±0.80 | S | 8.76±0.08 | R |
| 链霉素 Streptomycin | 10 | 6.00 | R | 12.13±0.23 | I |
| 新霉素 neomycin | 30 | 18.00±0.33 | S | 24.64±0.43 | S |
| 头孢克肟 Cefixine | 5 | 25.16±0.44 | S | 26.56±0.21 | S |
| 头孢克洛 Cefaclor | 30 | 26.67±0.68 | S | 22.02±0.36 | S |
| 头孢哌酮 Cefoperazone | 75 | 27.00±0.95 | S | 25.96±0.24 | S |
| 头孢拉定 Cefradine | 30 | 18.00±0.00 | S | 17.86±0.33 | S |
| 头孢他定 Ceftazidime | 30 | 27.50±1.06 | S | 22.10±0.18 | S |
| 头孢唑林 Cefazolin | 30 | 24.01±0.31 | S | 18.80±1.47 | S |
| 氨苄西林 Ampicilllin | 10 | 10.03±0.61 | R | 21.09±0.30 | S |
| 阿莫西林 Amoxicillin | 10 | 8.00±0.00 | R | 25.27±0.15 | S |
| 青霉素 Penicillin | 10 IU | 6.00 | R | 17.82±0.11 | S |
| 氯霉素 Chloramphenicol | 30 | 25.00±0.48 | S | 11.03±0.18 | S |
| 复方新诺明Co-trimoxazole | 1.25/23.75 | 6.00 | R | 16.55±0.11 | S |
| [1] | BAGLEY S T. Habitat association of Klebsiella species[J]. Infection Control & Hospital Epidemiology, 1985, 6(2): 52-58 |
| [2] | OLIVEIRA L, HULLAND C, RUEGG P L. Characterization of clinical mastitis occurring in cows on 50 large dairy herds in Wisconsin[J]. Journal of Dairy Science, 2013, 96(12): 7538-7549. |
| [3] | GAO J, BARKEMA H W, ZHANG L, et al. Incidence of clinical mastitis and distribution of pathogens on large Chinese dairy farms[J]. Journal of Dairy Science, 2017, 100(6): 4797-4806. |
| [4] | KRISHNAMOORTHY P, GOUDAR A L, SURESH K P, et al. Global and countrywide prevalence of subclinical and clinical mastitis in dairy cattle and buffaloes by systematic review and Meta-analysis[J]. Research in Veterinary Science, 2021, 136: 561-586. |
| [5] | PODDER M P, ROGERS L, DALEY P K, et al. Klebsiella species associated with bovine mastitis in newfoundland[J]. PLoS One, 2014, 9(9): e106518. |
| [6] | FUENZALIDA M J, RUEGG P L. Negatively controlled, randomized clinical trial to evaluate intramammary treatment of nonsevere, Gram-negative clinical mastitis[J]. Journal of Dairy Science, 2019, 102(6): 5438-5457. |
| [7] | SCHUKKEN Y, CHUFF M, MORONI P, et al. The "other" Gram-negative bacteria in mastitis: Klebsiella, Serratia, and more[J]. Veterinary Clinics of North America: Food Animal Practice, 2012, 28(2): 239-256. |
| [8] | PARAMASIVAM R, GOPAL D R, DHANDAPANI R, et al. Is AMR in dairy products a threat to human health? An updated review on the origin, prevention, treatment, and economic impacts of subclinical mastitis[J]. Infection and Drug Resistance, 2023, 16(null): 155-178. |
| [9] | GRIFFIN D. Bovine pasteurellosis and other bacterial infections of the respiratory tract[J]. The Veterinary Clinics of North America Food Animal Practice, 2010, 26(1): 57-71. |
| [10] | AMAT S, HOLMAN D B, TIMSIT E, et al. Evaluation of the nasopharyngeal microbiota in beef cattle transported to a feedlot, with a focus on lactic acid-producing bacteria[J]. Frontiers in Microbiology, 2019, 10:1988. |
| [11] | 于凡淞. 牛源溶血性曼氏杆菌和多杀性巴氏杆菌的分离与鉴定及生物学特性分析[D]. 武汉:华中农业大学,2024. |
| YU F S. Isolation and identification and biological characterisationof Manheimia haemolytica and Pasteurella multocida of bovine origin[D]. Wuhan: Huazhong Agricultural University, 2024. (in Chinese) | |
| [12] | 谢倩茹, 童胜涛, 邵咏旋, 等. 牛呼吸道感染细菌病原的致病机理与防控研究进展[J]. 中国兽医学报, 2016, 36(12): 2183-2188. |
| XIE Q R, TONG S T, SHAO Y X, et al. Research on pathogenic mechanism and prevention of bovine respiratory tract bacterial infection[J]. Chinese Journal of Veterinary Science, 2016, 36(12): 2183-2188. (in Chinese) | |
| [13] | WEISBURG W G, BARNS S M, PELLETIER D A, et al. 16S ribosomal DNA amplification for phylogenetic study[J]. Journal of Bacteriology, 1991, 173(2): 697-703. |
| [14] | YIN-CHING C, JER-HORNG S, CHING-NAN L, et al. Cloning of a gene encoding a unique haemolysin from Klebsiella pneumoniae and its potential use as a species-specific gene probe[J]. Microbial Pathogenesis, 2002, 33(1): 1-6. |
| [15] | RUSSO T A, OLSON R, FANG C T, et al. Identification of biomarkers for differentiation of hypervirulent Klebsiella pneumoniae from classical K. pneumoniae [J]. Journal of Clinical Microbiology, 2018, 56(9): e00776-18. |
| [16] | CANDAN E D, AKSÖZ N. Klebsiella pneumoniae: Characteristics of carbapenem resistance and virulence factors[J]. Acta Biochimica Polonica, 2015, 62(4): 867-874. |
| [17] | 邹鹏, 涂继军, 陈治权, 等. 骨科患者创面感染肺炎克雷伯菌耐药性及毒力特性研究[J]. 新乡医学院学报, 2021, 38(6): 534-539 |
| ZOU P, TU J J, CHEN Z Q, et al. Resistance and virulence characteristics of Klebsiella pneumoniae isolated from patients with wounds infection in department of orthopedics[J]. Journal of Xinxiang Medical University, 2021, 38(6): 534-539. (in Chinese) | |
| [18] | EL-DOMANY R A, AWADALLA O A, SHABANA S A, et al. Analysis of the correlation between antibiotic resistance patterns and virulence determinants in pathogenic Klebsiella pneumoniae isolates from Egypt[J]. Microbial Drug Resistance, 2021, 27(6): 727-739. |
| [19] | FERTAS-AISSANI R EL, MESSAI Y, ALOUACHE S, et al. Virulence profiles and antibiotic susceptibility patterns of Klebsiella pneumoniae strains isolated from different clinical specimens[J]. Pathologie Biologie, 2013, 61(5): 209-216. |
| [20] | 徐水宝, 杨思宇, 翁珊珊, 等. 高毒力肺炎克雷伯菌血清型、毒力基因分布及分子标志物探索[J]. 微生物与感染, 2019, 14(6): 338-344. |
| XU S B, YANG S Y, WENG S S, et al. Distribution of serotypes and virulence genes in hypervirulent Klebsiella pneumoniae and exploration of molecular markers[J]. Journal of Microbes and Infections, 2019, 14(6): 338-344. (in Chinese) | |
| [21] | 和晋渝. 肺炎克雷伯菌的血清分型及毒力基因分布的研究[D]. 重庆:重庆医科大学,2012. |
| HE J Y. Study on serotypes and distribution characteristic of virulence genes of Klebsiella pneumoniae [D]. Chongqing: Chongqing Medical University, 2012. (in Chinese) | |
| [22] | 高淩. 高毒力耐碳青霉烯类肺炎克雷伯菌形成的分子机制研究[D].昆明:昆明医科大学, 2019. |
| GAO L. Molecular mechanism of carbampenem-resistance hypervirulent Klebsiella pneumoniae [D]. Kunming: Kunming Medical University, 2019. (in Chinese) | |
| [23] | CLSI. Performance standards for antimicrobial disk and dilution susceptibility tests for bacteria isolated from animals (6th ed.). CLSI supplement VET01S [S]. Clinical and Laboratory Standards Institute, 2023. |
| [24] | 庞晓敏. 不同宿主来源的肺炎克雷伯菌耐药性及毒力评估[D]. 武汉:华中农业大学, 2023. |
| PANG X M. Evaluation of drug resistance and virulence of Klebsiella pneumoniae from different host origins[D]. Wuhan: Huazhong Agricultural University, 2023. (in Chinese) | |
| [25] | 买尔哈巴·吾斯曼. 国内部分地区奶牛乳腺炎源肺炎克雷伯菌生物学特性研究[D]. 阿拉尔:塔里木大学, 2022. |
| MAIERHABA·WUSIMAN. Study on biological characteristics of Klebsiella pneumoniae from cow mastitis in some areas of China[D]. Alar: Tarim University, 2022. (in Chinese) | |
| [26] | 吴欣悦. 苏北部分牧场奶牛乳腺炎源肺炎克雷伯菌流行病学调查及其毒力基因与耐药性相关性分析[D]. 扬州:扬州大学, 2023. |
| WU X Y. Epidemiological investigation of Klebsiella pneumoniae of bovine mastitis in farms of Northern Jiangsu and analysis of the correlation between virulence genes and drug resistance[D]. Yangzhou: Yangzhou University, 2023. (in Chinese) | |
| [27] | MA Q, ZHU Z, LIU Y, et al. Keeping alert to the hypervirulent K1, K2, K3, K5, K54 and K57 strains of Klebsiella pneumoniae within dairy production process[J]. Microbes and Infection, 2023, 25(5): 105106. |
| [28] | 于凡淞,赵梦莹,熊丽雯,等.牛源溶血性曼氏杆菌和多杀性巴氏杆菌的分离与鉴定[J].微生物学通报,2025, 52(3): 1281-1294. |
| YU F S, ZHAO M Y, XIONG L W, et al. Isolation and identification of bovine-origin Mannheimia haemolytica and Pasteurella multocida [J]. Microbiology China, 2025, 52(3): 1281-1294. (in Chinese) | |
| [29] | 李海源. 肺炎克雷伯菌乳房炎的致病机理及其耐药性分析[J]. 中国乳业, 2023,11:39-44. |
| LI H Y. Pathogenic mechanism and drug resistance analysis of Klebsiella pneumoniae mastitis[J]. China Dairy, 2023,11:39-44. (in Chinese) | |
| [30] | CHENG J, ZHANG J, HAN B, et al. Klebsiella pneumoniae isolated from bovine mastitis is cytopathogenic for bovine mammary epithelial cells[J]. Journal of Dairy Science, 2020, 103(4): 3493-3504. |
| [31] | LIN W F, HU R Y, CHANG H Y, et al. The role of urease in the acid stress response and fimbriae expression in Klebsiella pneumoniae CG43[J]. Journal of Microbiology, Immunology and Infection, 2022, 55(4): 620-633. |
| [32] | YANG Y, HIGGINS C H, REHMAN I, et al. Genomic diversity, virulence, and antimicrobial resistance of Klebsiella pneumoniae strains from cows and humans[J]. Applied and Environmental Microbiology, 2019, 85(6):e02654-18. |
| [33] | HOLDEN V I, BACHMAN M A. Diverging roles of bacterial siderophores during infection[J]. Metallomics, 2015, 7(6): 986-995. |
| [34] | 吴香云. 湖北地区奶牛乳房炎源肺炎克雷伯菌毒力和耐药分子特征研究[D]. 武汉: 华中农业大学, 2023. |
| WU X Y. Study on molecular characteristics of virulence and resistanceof Klebsiella pneumoniae from mastitis cows in Hubei[D]. Wuhan: Huazhong Agricultural University, 2023. (in Chinese) | |
| [35] | 常攀. 西藏牦牛源克雷伯菌的生物学特性及全基因组分析[D]. 林芝:西藏农牧学院, 2023. |
| CHANG P. Biological characteristics and whole genome analysis of Klebsiella from yak in Tibet[D]. Linzhi: Tibet Agricultural and Animal Husbandry University, 2023. (in Chinese) | |
| [36] | SINGH K, RITCHEY J W, CONFER A W. Mannheimia haemolytica: Bacterial-host interactions in bovine pneumonia[J]. Veterinary Pathology, 2011, 48(2): 338-348. |
| [37] | GRIFFIN D, CHENGAPPA M M, KUSZAK J, et al. Bacterial pathogens of the bovine respiratory disease complex[J]. Veterinary Clinics of North America: Food Animal Practice, 2010, 26(2): 381-394. |
| [38] | KAYAL A, NAHAR N, BARKER L, et al. Molecular identification and characterisation of Mannheimia haemolytica [J]. Veterinary Microbiology, 2024, 288: 109930. |
| [39] | ABDULKADIR M, NIGUSSIE T, KEBEDE I A. Isolation and identification of Pasteurella multocida and Mannheimia haemolytica from pneumonic small ruminants and their antibiotic susceptibility in Haramaya district, Eastern Ethiopia[J]. The Scientific World Journal, 2024, 2024: 5605552. |
| [40] | GARCÍA-ALVAREZ A, FERNÁNDEZ-GARAYZÁBAL J F, CHAVES F, et al. Ovine Mannheimia haemolytica isolates from lungs with and without pneumonic lesions belong to similar genotypes[J]. Veterinary Microbiology, 2018, 219: 80-86. |
| [41] | YANG Y, PENG Y, JIANG J, et al. Isolation and characterization of multidrug-resistant Klebsiella pneumoniae from raw cow milk in Jiangsu and Shandong provinces, China[J]. Transboundary and Emerging Diseases, 2021, 68(3): 1033-1039. |
| [42] | SONG S, HE W, YANG D, et al. Molecular epidemiology of Klebsiella pneumoniae from clinical bovine mastitis in Northern area of China, 2018-2019[J]. Engineering, 2022, 10: 146-154. |
| [43] | 冯娜, 高翔, 肖敏, 等. 牛源肺炎克雷伯氏菌的分离鉴定及遗传进化分析[J]. 中国兽医科学, 2016, 46(11): 1358-1364. |
| FENG N, GAO X, XIAO M, et al. Isolation, identification, and genetic evolution analysis of bovine-derived Klebsiella pneumoniae [J]. Chinese Veterinary Science, 2016, 46(11): 1358-1364. (in Chinese) | |
| [44] | PAULIN-CURLEE G G, SINGER R S, SREEVATSAN S, et al. Genetic diversity of mastitis-associated Klebsiella pneumoniae in dairy cows[J]. Journal of Dairy Science, 2007, 90(8): 3681-3689. |
| [45] | 王亨, 孟霞, 邱昌伟, 等. 肺炎克雷伯氏菌对荷斯坦奶牛乳腺上皮细胞黏附和侵袭的体外研究[J]. 畜牧兽医学报, 2008, 39(4): 494-498. |
| WANG H, MENG X, QIU C W, et al. In vitro study on adhesion and invasion of Klebsiella pneumoniae to Holstein dairy cow mammary epithelial cells[J]. Acta Veterinaria et Zootechnica Sinica, 2008, 39(4): 494-498. (in Chinese) | |
| [46] | SONG J, XIANG W, WANG Q, et al. Prevalence and risk factors of Klebsiella spp. in milk samples from dairy cows with mastitis—A global systematic review[J]. Frontiers in Veterinary Science, 2023, 10: 1143257. |
| [47] | LEI T Y, LIAO B B, YANG L R, et al. Hypervirulent and carbapenem-resistant Klebsiella pneumoniae: A global public health threat[J]. Microbiological Research, 2024, 288: 127839. |
| [48] | BRAUN H G, PERERA S R, TREMBLAY Y D N, et al. Antimicrobial resistance in Klebsiella pneumoniae: An overview of common mechanisms and a current Canadian perspective[J]. Canadian Journal of Microbiology, 2024, 70(12): 507-528. |
| [49] | GARCÍA-COBOS S, OTEO-IGLESIAS J, PÉREZ-VÁZQUEZ M. Hypervirulent Klebsiella pneumoniae: Epidemiology outside Asian countries, antibiotic resistance association, methods of detection and clinical management[J]. Enfermedades Infecciosasy Microbiología Clínica (English Edition), 2025, 43(2): 102-109. |
| [1] | Min ZHANG, Yingxiao LI, Lulu ZHANG, Shuhai HE, Zhehui QU, Dongsheng QIN, Jicheng LIU, Fengchao JIAO. Whole Genome Amplification and Phylogenetic Analysis of Duck Astrovirus Type 1 Xinyang Strain [J]. China Animal Husbandry & Veterinary Medicine, 2026, 53(2): 959-972. |
| [2] | Xiaohan WANG, Huiguang WU, Lijing REN, Jiangnan ZHAO, Miao LIN, Jingwen ZHAO. Effects of Glycerol Monolaurate on Growth Performance, Rumen Fermentation Parameters, Serum Biochemical Indices, and Gas Emissions in Dairy Cows [J]. China Animal Husbandry & Veterinary Medicine, 2026, 53(1): 179-189. |
| [3] | Xinxin ZHANG, Yue ZHANG, An CUI, Jinru LI, Yunjing ZHANG, Lixia HE, Guijun YANG, Yudong REN, Guangxing LI. Isolation, Identification and Genetic Evolution Analysis of PEDV Epidemic Strains in Heilongjiang Province [J]. China Animal Husbandry & Veterinary Medicine, 2026, 53(1): 378-389. |
| [4] | Kaiqi LIAN, Yuhang WANG, Xiangfeng MENG, Mingliang ZHANG, Lingling ZHOU. Isolation, Identification and Drug Resistance Analysis of Pathogenic Escherichia coli from Pavo cristatus [J]. China Animal Husbandry & Veterinary Medicine, 2026, 53(1): 448-458. |
| [5] | Ya WANG, Zhiguo LI, Rongyan LUO, Ruiguo LIU, Zhicai ZUO, Xiaoping MA. Isolation, Identification, Phylogenetic Analysis and Drug Sensitivity Test of Trichophyton verrucosum from Beef Cattle in Sichuan [J]. China Animal Husbandry & Veterinary Medicine, 2026, 53(1): 459-468. |
| [6] | Qilin WANG, Runlai CAO, Peiwen LIU, Ziyu LIU, Zhuqing XUE, Haixia DU, Yue ZHANG, Minjing ZHANG, Yacong LI, Weiyang WANG, Yanfang CONG, Xiaoxu WANG, Zhijie LIU. Isolation, Identification and Biological Characteristics Analysis of Bordetella bronchiseptica from Raccoon dog(Nyctereutes procyonoides) [J]. China Animal Husbandry & Veterinary Medicine, 2026, 53(1): 489-498. |
| [7] | Fuxiang LI, Jianling SONG, Zhanhong LI. Isolation, Identification and Biological Characterization of Actinobacillus pleuropneumoniae Serotype 7 from Pigs in Yunnan [J]. China Animal Husbandry & Veterinary Medicine, 2026, 53(1): 499-508. |
| [8] | PANG Xiaotong, KUANG Yu, GENG Mingyang, NAN Shanshan, MA Xiaoxue, WEI Xin, XIE Song, NIE Cunxi. Effect of Compound Enzyme Preparation on Nutrient Digestibility, Milk Composition, Rumen Fermentation Parameters and Bacterial Flora of Periparturient Dairy Cows [J]. China Animal Husbandry & Veterinary Medicine, 2025, 52(8): 3607-3619. |
| [9] | WANG Zhengxing, HU Ximin, LUORENG Zhuoma, WANG Xingping. Regulatory Effects of Omega-3 Fatty Acids on Mastitis, Reproductive Performance and Milk Production Performance in Dairy Cows [J]. China Animal Husbandry & Veterinary Medicine, 2025, 52(8): 3672-3682. |
| [10] | ZHAO Xuejian, CHEN Xiaoliang, FENG Xiaowei, ZHANG Kang, MA Xiaojun, LI Jianxi. Investigation of the Pathogen of Calf Diarrhea in Gansu Region and Isolation, Identification and Drug Resistance Analysis of Clostridium perfringens [J]. China Animal Husbandry & Veterinary Medicine, 2025, 52(8): 3927-3938. |
| [11] | DAI Lin, HUAI Zhifang, WANG Baowei, ZHANG Ming'ai, FAN Wenlei, ZHANG Jing, WANG Binghan, QI Guofeng. Isolation, Identification and Biological Properties and Safety of A Lactiplantibacillus plantarum Strain [J]. China Animal Husbandry & Veterinary Medicine, 2025, 52(7): 3070-3083. |
| [12] | ZHAO Jinghong, MA Hui, LIU Jintao, MIAO Renfang, LIU Hongzhi, LIU Duncheng, QU Yongli. Effects of Supplemental Light on Blood Endocrine Hormone Concentrations and Circadian Rhythm Changes in Late-gestation Holstein Breeding Dairy Cows [J]. China Animal Husbandry & Veterinary Medicine, 2025, 52(7): 3178-3189. |
| [13] | LU Chong, WANG Yuyan, FU Han, LI Tongyang, MIAO Ronghao, LU Yabin, LI Jianlong, LIU Jianhua, GUO Qingyong, MAI Zhanhai, KUANG Ling. Isolation and Identification of the Main Pathogenic Bacteria of Aborted Yili Foals and Their Pathogenicity [J]. China Animal Husbandry & Veterinary Medicine, 2025, 52(7): 3344-3358. |
| [14] | ZHAO Yilong, TANG Na, JING Changhua, XU Qingqing, YIN Xiusheng, WANG Haiming, SUN Jing, LIN Panpan, DONG Lin, LIU Jishan, CAO Rongfeng. Isolation,Identification and Biological Characteristics of a Strain of Lumpy Skin Disease Virus [J]. China Animal Husbandry & Veterinary Medicine, 2025, 52(6): 2790-2799. |
| [15] | YANG Qinhong, YANG Jia, DUAN Wenjie, ZHANG Yongxian, ZHU Youshuai, YANG Shaohong, HE Cheng, YIN Hongbin, LI Suhua. Isolation and Identification of a High-temperature Tolerant Bacillus thermoamylovorans and Optimization of Its Enzyme Production Conditions [J]. China Animal Husbandry & Veterinary Medicine, 2025, 52(6): 2839-2850. |
| Viewed | ||||||
|
Full text |
|
|||||
|
Abstract |
|
|||||